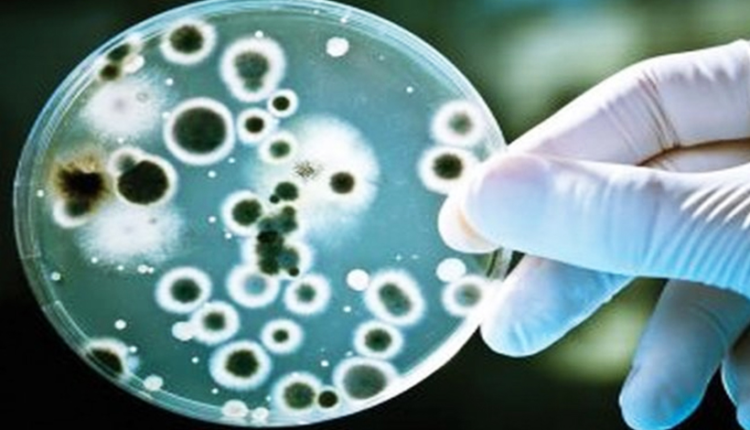

0 555 339 7979 - 0 532 708 30 04
Mevcut ilaçlara dirençli patojenler üzerinde de etkili doğal bir antibiyotik buldular.
Devrim niteliğinde bir antibiyotik keşfi yaptık..
Rusya: Devrim niteliğinde bir antibiyotik keşfi yaptık.
Rus Tümen Devlet Üniversitesi’nden bilim insanları, mevcut ilaçlara dirençli patojenler üzerinde de etkili doğal bir antibiyotik bulduklarını duyurdu.
Rus Tümen Devlet Üniversitesi’nden bilim insanları, mevcut ilaçlara dirençli patojenler üzerinde de etkili doğal bir antibiyotik bulduklarını duyurdu.
Bilim insanlarının ilgili çalışması Applied Biochemistry and Microbiology (Uygulamalı Biyokimya ve Mikrobiyoloji) adlı dergide yayınlandı.
Türkrus’un haberine göre; çalışmanın yazarları bulunan maddenin insanlarda ve hayvanlarda hastalığa sebep olan pek çok bakteri ve mantara karşı etkinlik gösterdiği dile getirildi.
Çalışmada Lipopeptide Emericellipsin A olarak adlandırılan antibiyotiğin from Emericellopsis alkalina adlı mantardan izole edildiği bilgisi yer alıyor.
Antibiyotiğin bakterilerin biyofilm oluşturmasına engel olarak ilaçlara direncini ortadan kaldırdığı bildiriliyor.
Bilim insanları bir sonraki aşamada keşfedilen antibiyotiğin laboratuvar testlerinin yapılacağını açıkladı.